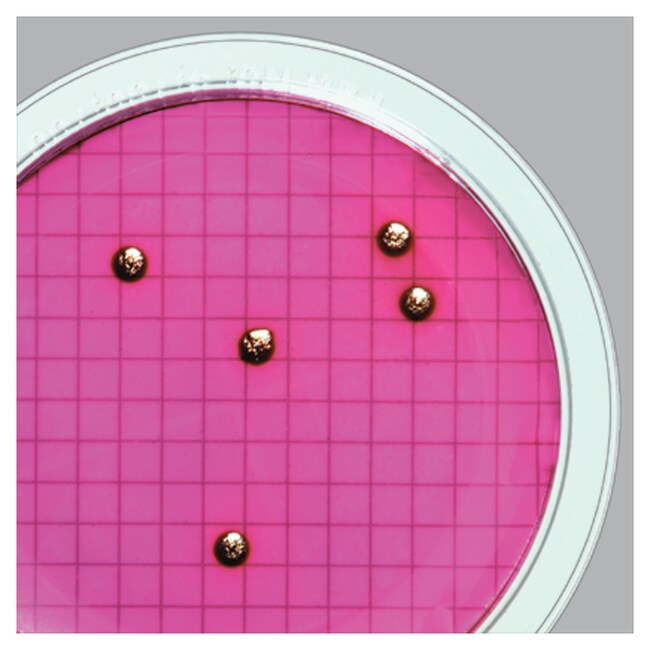
WaterBugs&trade; 大肠杆菌菌株 C1

Search
Search
| Catalog Number | Quantity |
|---|---|
| R4751985 | 10 Tests/Kit |
Thermo Scientific™ WaterBugs Escherichia coli Strain C1 is used for water/wastewater quality control testing; microorganisms are supplied in Quanti-Cult format.
Ordering Alerts:
Supplied with 10 preserved organism vials; 10 rehydration vials.